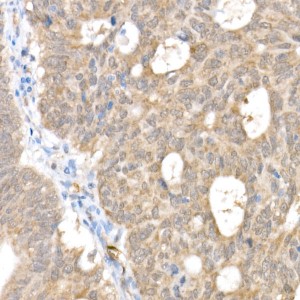
KO-Validated Smad1 Rabbit mAb (20 μl)

| Reactivity: | Human, Mouse |
| Applications: | WB, IHC, IP, ELISA |
| Host Species: | Rabbit |
| Isotype: | IgG |
| Clonality: | Monoclonal antibody |
| Gene Name: | SMAD family member 1 |
| Gene Symbol: | SMAD1 |
| Synonyms: | BSP1; JV41; BSP-1; JV4-1; MADH1; MADR1; d1 |
| Gene ID: | 4086 |
| UniProt ID: | Q15797 |
| Clone ID: | 4E1G5 |
| Immunogen: | Recombinant fusion protein containing a sequence corresponding to amino acids 20-240 of human Smad1 (NP_005891.1). |
| Dilution: | WB 1:500-1:2000; IF/IC 1:50-1:200 |
| Purification Method: | Affinity purification |
| Concentration: | 1.00 mg/mL |
| Buffer: | PBS with 0.05% proclin300, 0.05% BSA, 50% glycerol, pH7.3. |
| Storage: | Store at -20°C. Avoid freeze / thaw cycles. |
| Documents: | Manual-SMAD1 monoclonal antibody |
Background
The protein encoded by this gene belongs to the SMAD, a family of proteins similar to the gene products of the Drosophila gene 'mothers against decapentaplegic' (Mad) and the C. elegans gene Sma. SMAD proteins are signal transducers and transcriptional modulators that mediate multiple signaling pathways. This protein mediates the signals of the bone morphogenetic proteins (BMPs), which are involved in a range of biological activities including cell growth, apoptosis, morphogenesis, development and immune responses. In response to BMP ligands, this protein can be phosphorylated and activated by the BMP receptor kinase. The phosphorylated form of this protein forms a complex with SMAD4, which is important for its function in the transcription regulation. This protein is a target for SMAD-specific E3 ubiquitin ligases, such as SMURF1 and SMURF2, and undergoes ubiquitination and proteasome-mediated degradation. Alternatively spliced transcript variants encoding the same protein have been observed.
Images
 | Western blot analysis of various lysates using [KO Validated] Smad1 Rabbit mAb (A22326) at1:1000 dilution. Secondary antibody: HRP-conjugated Goat anti-Rabbit IgG (H+L) (AS014) at1:10000 dilution. Lysates/proteins: 25μg per lane. Blocking buffer: 3% nonfat dry milk in TBST. Detection: ECL Basic Kit (RM00020). Exposure time: 90s. |
 | Western blot analysis of lysates from wild type(WT) and Smad1 knockout (KO) HeLa cells, using [KO Validated] Smad1 Rabbit mAb (A22326) at 1:1000 dilution. Secondary antibody: HRP-conjugated Goat anti-Rabbit IgG (H+L) (AS014) at 1:10000 dilution. Lysates/proteins: 25μg per lane. Blocking buffer: 3% nonfat dry milk in TBST. Detection: ECL Basic Kit (RM00020). Exposure time: 180s. |
 | Immunohistochemistry analysis of paraffin-embedded Human colon carcinoma using [KO Validated] Smad1 Rabbit mAb (A22326) at dilution of 1:100 (40x lens). High pressure antigen retrieval performed with 0.01M Citrate Bufferr (pH 6.0) prior to IHC staining. |
 | Immunoprecipitation analysis of 600 μg extracts of Mouse lung using 3 μg Smad1 antibody (A22326). Western blot was performed from the immunoprecipitate using Smad1 antibody (A22326) at a dilution of1:1000. |
You may also be interested in: